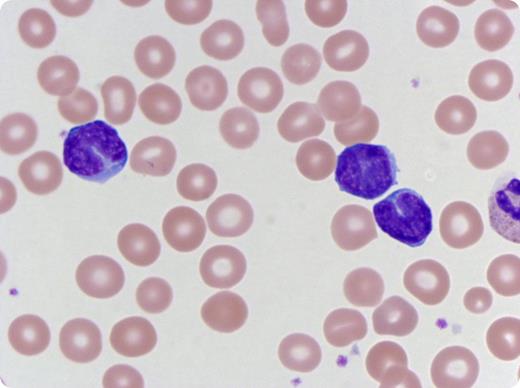
A 2-month-old girl, who was current on her immunizations and had no prior illness, presented to the emergency department with a 2-week history of progressive cough and shortness of breath. A chest radiograph revealed bilateral peribronchial thickening. Complete blood count results revealed a white blood cell count of 38.6 × 109/L (71% lymphocytes, 19% segmented neutrophils, 6% monocytes, 3% bands, and 1% metamyelocytes); hemoglobin level was 10.7 g/dL, and platelet level was 425 × 109/L. Morphologic examination of the peripheral blood smear revealed numerous mature lymphocytes with scant cytoplasm, condensed chromatin, and clefted nuclei—characteristic of Bordetella pertussis lymphocytosis. Real-time polymerase chain reaction was positive for B pertussis and negative for respiratory syncytial virus and influenza A and B. The patient was treated with azithromycin and prednisolone. / Pertussis has a wide spectrum of presentation, and a high index of suspicion must be maintained. Analyzing culture is the gold standard for diagnosis; however, polymerase chain reaction is a rapid and more sensitive test. Studies of pertussis in children show absolute lymphocytosis in >50% of patients, and characteristic small, mature lymphocytes with hyperchromatic, cleaved nuclei may account for as much as 56% (12%-56%; mean, 31%) of total lymphocytes. This case emphasizes the importance of peripheral blood smear evaluation as a diagnostic tool until other results become available.

A 2-month-old girl, who was current on her immunizations and had no prior illness, presented to the emergency department with a 2-week history of progressive cough and shortness of breath. A chest radiograph revealed bilateral peribronchial thickening. Complete blood count results revealed a white blood cell count of 38.6 × 109/L (71% lymphocytes, 19% segmented neutrophils, 6% monocytes, 3% bands, and 1% metamyelocytes); hemoglobin level was 10.7 g/dL, and platelet level was 425 × 109/L. Morphologic examination of the peripheral blood smear revealed numerous mature lymphocytes with scant cytoplasm, condensed chromatin, and clefted nuclei—characteristic of Bordetella pertussis lymphocytosis. Real-time polymerase chain reaction was positive for B pertussis and negative for respiratory syncytial virus and influenza A and B. The patient was treated with azithromycin and prednisolone.
Pertussis has a wide spectrum of presentation, and a high index of suspicion must be maintained. Analyzing culture is the gold standard for diagnosis; however, polymerase chain reaction is a rapid and more sensitive test. Studies of pertussis in children show absolute lymphocytosis in >50% of patients, and characteristic small, mature lymphocytes with hyperchromatic, cleaved nuclei may account for as much as 56% (12%-56%; mean, 31%) of total lymphocytes. This case emphasizes the importance of peripheral blood smear evaluation as a diagnostic tool until other results become available.
A 2-month-old girl, who was current on her immunizations and had no prior illness, presented to the emergency department with a 2-week history of progressive cough and shortness of breath. A chest radiograph revealed bilateral peribronchial thickening. Complete blood count results revealed a white blood cell count of 38.6 × 109/L (71% lymphocytes, 19% segmented neutrophils, 6% monocytes, 3% bands, and 1% metamyelocytes); hemoglobin level was 10.7 g/dL, and platelet level was 425 × 109/L. Morphologic examination of the peripheral blood smear revealed numerous mature lymphocytes with scant cytoplasm, condensed chromatin, and clefted nuclei—characteristic of Bordetella pertussis lymphocytosis. Real-time polymerase chain reaction was positive for B pertussis and negative for respiratory syncytial virus and influenza A and B. The patient was treated with azithromycin and prednisolone.
Pertussis has a wide spectrum of presentation, and a high index of suspicion must be maintained. Analyzing culture is the gold standard for diagnosis; however, polymerase chain reaction is a rapid and more sensitive test. Studies of pertussis in children show absolute lymphocytosis in >50% of patients, and characteristic small, mature lymphocytes with hyperchromatic, cleaved nuclei may account for as much as 56% (12%-56%; mean, 31%) of total lymphocytes. This case emphasizes the importance of peripheral blood smear evaluation as a diagnostic tool until other results become available.
For additional images, visit the ASH IMAGE BANK, a reference and teaching tool that is continually updated with new atlas and case study images. For more information visit http://imagebank.hematology.org.

This feature is available to Subscribers Only
Sign In or Create an Account Close Modal